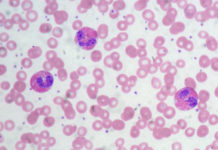

Συχνά επιχειρήματα κατά των εμβολιασμών
Αντιδράσεις κατά των εμβολιασμών υπάρχουν από την εισαγωγή του εμβολιασμού κατά της ευλογιάς στις αρχές του 19ου αιώνα. Οι λόγοι για τους οποίους σταμάτησε...
Η νόσος χεριών, ποδιών και στόματος στα παιδιά
Η νόσος των χεριών, ποδιών και στόματος είναι μία αβλαβής, αλλά πολύ μεταδοτική ιογενής λοίμωξη, που πλήττει κυρίως τα παιδιά μέχρι την ηλικία των...
Σύνδρομο κυκλικών εμετών
Ορισμός
Το σύνδρομο κυκλικών εμετών-μερικές φορές αναφέρεται ως ΣΚΕ-είναι μια διαταραχή που αναγνωρίζεται όλο και περισσότερο, με ξαφνικά, επαναλαμβανόμενα επεισόδια σοβαρής ναυτίας, εμετού, και σωματικής...
Ουδετεροπενίες στα παιδιά
Ουδετεροπενία είναι μια διαταραχή που χαρακτηρίζεται από χαμηλό αριθμό ουδετερόφιλων ή πολυμορφοπύρηνων λευκών κυττάρων. Τα ουδετερόφιλα αποτελούν το 50-70% του συνόλου των λευκών κυττάρων...
Baby sitter 40 ιντσών
Όσο κι αν την κατηγορούμε, όσο κι αν αποτρέπουμε τα παιδιά από τη συντροφιά της, η τηλεόραση είναι πάντα στο σπίτι μας, πάντα πειρασμός...
Οι ανοιξιάτικες αλλεργίες
Οι αλλεργίες της άνοιξης έχουν ως κύριο σύμπτωμα την αλλεργική ρινίτιδα (αλλεργία από τη γύρη , εποχιακή αλλεργική ρινίτιδα)
Η αλλεργική ρινίτιδα όπως και το αλλεργικό...
Έσω στροφή βαδίσματος
Χειρουργείο η αντίστροφα παπούτσια στην έσω στροφή βαδίσματος (INTOEGAIT): Πρόβλημα η Μύθος?
Πως το αντιμετωπίζουμε οι γονείς?
Τι είναι εσωστροφή βαδίσματος (ΕΣΒ)? Είναι όταν το παιδί...
Εκμάθηση των χρωμάτων στά παιδιά
Τα χρώματα είναι μια γνωστική, διασκεδαστική δραστηριότητα όπου διδάσκουμε στα παιδιά. Τα παιδιά πρώτα μαθαίνουν να κατονομάζουν όλες τις έννοιες επιδεκτικά και μετά μαθαίνουν...
Διαταραχή ελλειμματικής Προσοχής και Υπερκινητικότητας (ΔΕΠ-Υ)
Η διαταραχή ελλειμματικής προσοχής/υπερκινητικότητας (ΔΕΠ-Υ), είναι η πιο συχνή αναπτυξιακή διαταραχή που αναφέρεται σε παιδιά και εφήβους. Τα χαρακτηριστικά αυτής της διαταραχής είναι η...
Λογοπαθολογική αξιολόγηση
Τι είναι και γιατί είναι απαραίτητη για τον προσδιορισμό των θεραπευτικών στόχων
Η λογοθεραπευτική αξιολόγηση είναι η διαδικασία κατά την οποία ο Λογοπαθολόγος εξετάζει και...